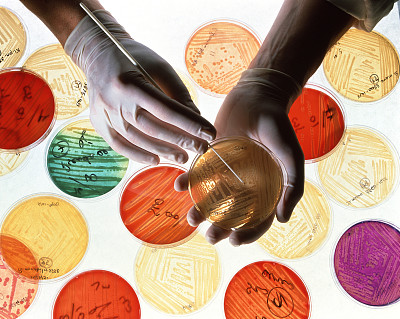
中美基建或提振天胶需求 橡胶期货反弹还需等待

中美基建或提振天胶需求 橡胶期货反弹还需等待
集金 期货 通02月07日消息:当前橡胶期货仍然趴在底部,回暖还需数日。
2017年,以螺纹钢(3945, -15.00, -0.38%)为代表的黑色品种大放异彩,以铜为代表的有色品种亦表现不俗,但橡胶(12655, -120.00, -0.94%)却始终趴在底部。近期,沪胶不断走低。
基本面仍处于困境中
从供应角度分析,本世纪初的橡胶价格大涨引发了东南亚诸多产胶国的扩产冲动。自2005年开始,ANRPC的年新种面积保持在20万公顷以上,这一势头一直持续到2012年。橡胶的种植周期约为7年,即种下去的树大约7年之后才能进入开割。从这一角度来说,2005—2012年新种的胶树正在持续不断地向市场施加供应压力。
从需求角度分析,主要关注轮胎产量变化。2017年,轮胎产量增速下滑明显,在大多数月份同比增速在5%以下。而2016年,该数字数月保持在10%以上。此外,无论是保税区库存还是上期所库存,均保持上升势头。保税区库存在去年9月触底,此后连续上升,至今年1月中旬接近25万吨,比前期低点上涨了30%以上。上期所库存在旧仓单注销之前最高达到51万吨,仓单注销之后降至32.2万吨,但之后快速增加,截至2月初已经上升至42.6万吨。
政策干预效果不可忽视
ITRC在2017年12月达成了协议,限制主产国出口橡胶34.9万吨。其中,泰国23.4万吨,印尼9.5万吨,马来西亚2万吨。
泰国也出台了相应的天胶价格提振方案,一是低息贷款收购35万吨天胶,二是国内消耗20万吨天胶;三是减少天胶种植面积,影响产量11万吨。目标是把胶价推升至65泰铢/公斤。
产胶国出台的政策虽然对胶价的上涨没有起到立竿见影的效果,但仍然不可忽视。
中美基建或拉升天胶需求
在完成大规模减税计划之后,未来美国或迎来大基建计划的实施。而如果这一计划能够得到较好的执行,那么毫无疑问将大幅度推升天胶的需求,并有望就此抬高胶价。而中国的一带一路,也必然带来较大的基建需求。基建的发展对天胶需求有着重要的拉升作用。因此,我们认为未来天胶需求可能会得到改善。但这还需要更长时间来验证。
总体而言,橡胶目前的价格已经在一定程度上反映了疲弱的基本面。短期内沪胶在技术上有可能继续延续弱势,但下方空间有限。
下载关注集金期货通APP,查看实时期货行情走势,获取权威 期货投资 信息!



